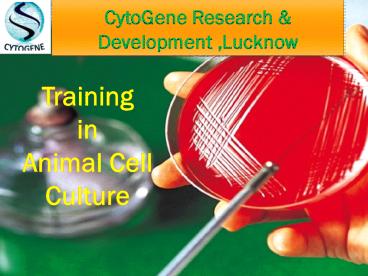

Training in animal cell culture in U.P PowerPoint PPT Presentation
Title: Training in animal cell culture in U.P
1
- CytoGene Research Development ,Lucknow
Training in Animal Cell Culture
2
CytoGene Research Development
PROVIDES
- Training in Animal Cell Culture
3
what is Animal Cell Culture?
Animal Cell culture is the complex process by
which cells are grown under controlled
conditions, generally outside of their natural
environment. In practice, the term "cell culture"
now refers to the culturing of cells derived from
multi-cellular eukaryotes, especially animal
cells. However, there are also cultures of
plants, fungi and microbes, including viruses,
bacteria and protists. The historical development
and methods of cell culture are closely
interrelated to those of tissue culture and organ
culture.
4
CytoGene Research Development
- CytoGene,provides several modules of training
as well as dissertation/project in Animal Cell
Culture Technology. The duration of the programs
offered for training ranges from 7 to 30 days and
for project ranges from 3-6 months. Modules are
selected by the students on their choice.
5
15-Days Training In Animal Cell Culture
- Preparation of Media
- Preparation of Sera
- Primary culture of chick embryo fibroblast
- Sub culture of primary culture
- Passaging to obtained pure culture
- Primary culture of fish epithelial cell
- Sub culture of primary culture of fish epithelial
cell - Preservation of cells
- Visualization under inverted microscope
6
30-Days Training In Animal Cell Culture
- Preparation of Media
- Preparation of Sera
- Primary culture of chick embryo fibroblast
- Sub culture of primary culture
- Passaging to obtained pure culture
- Primary culture of fish epithelial cell
- Sub culture of primary culture of fish epithelial
cell - Preservation of cells
- Visualization under inverted microscope
- Organ culture, Fibroblast culture.
- Study of effect of anti-cancer agent in cell
culture - MTT Assay
- Live cell counting
- Leukocyte culture
- Culturing of spleen cells
- Myeloma cell culture
- Fusion of cells by PEG
7
PROJECT /DISSERTATION
We offer four different categories of
Project/dissertation work depending upon the
duration of the project.
- Mini Project
- Duration 40 45 Days
- Economic Project
- Duration 2 6 month
- Academic project
- Duration 2 6 month
- Extensive project
- Duration 2 6 month
8
HOW TO APPLY
- Choose the topic for Training/Project/Dissertation
- Download the Registration Form from our website
(www.cytogene.in). Fill it carefully. - Attach a copy of CV (Resume)
- Attach Recommendation Letter issued by Department
or Higher Authority. - Send the document to us
- By Email Send scanned document to
project.cytogene_at_gmail.com or director.cytogene_at_gm
ail.com - By Whatsapp Send the snap shot of each document
to 8756658021. - By Post Send the complete document to The
Director, CytoGene Research Development, 2nd
Floor, B-1655, B-Block Chauraha, Indira Nagar,
Lucknow 226016. - By Visiting us Submit the document by visiting
us at our office. - The Selected candidate would be informed through
email.
9
How to Register ?
Selected Candidate can Register by paying 500/-
(Registration fees) towards confirmation of
seat. Mode of Payment By DD A Demand Draft of
2,000/- in the favor of CytoGene Research and
Development LLP, payable at Lucknow. This
amount of 2,000/- will be adjusted in the total
fee. Send the DD to The Director, CytoGene
Research Development, 2nd Floor, B-1655,
B-Block Chauraha, Indira Nagar, Lucknow
226016 By Depositing in Bank/Online Transfer
You can deposit/transfer the registration amount
to our current account Name CytoGene Research
Development LLP, A/C 126405000317, IFSC Code
ICIC0001264 Branch Faizabad Road Branch, Lekhraj
Khajana Complex, Indira Nagar, Lucknow226016.
By Cash The registration fee can be submitted
by visiting to our Office. Confirmation letter
will be sent after receiving the registration
fee. The remaining fee can be paid during the
joining of the candidate for Dissertation.
10
FIND US ON SOCIAL MEDIA
www.facebook.com/CytoGene
https//plus.google.com/CytogeneInlucknow
https//twitter.com/Lucknow_226016
https//www.youtube.com/channel/UCOXn4sBZGmYN9Qihv
h4nOYA
www.cytogene.com
11
Thank You
http//cytogene.in/